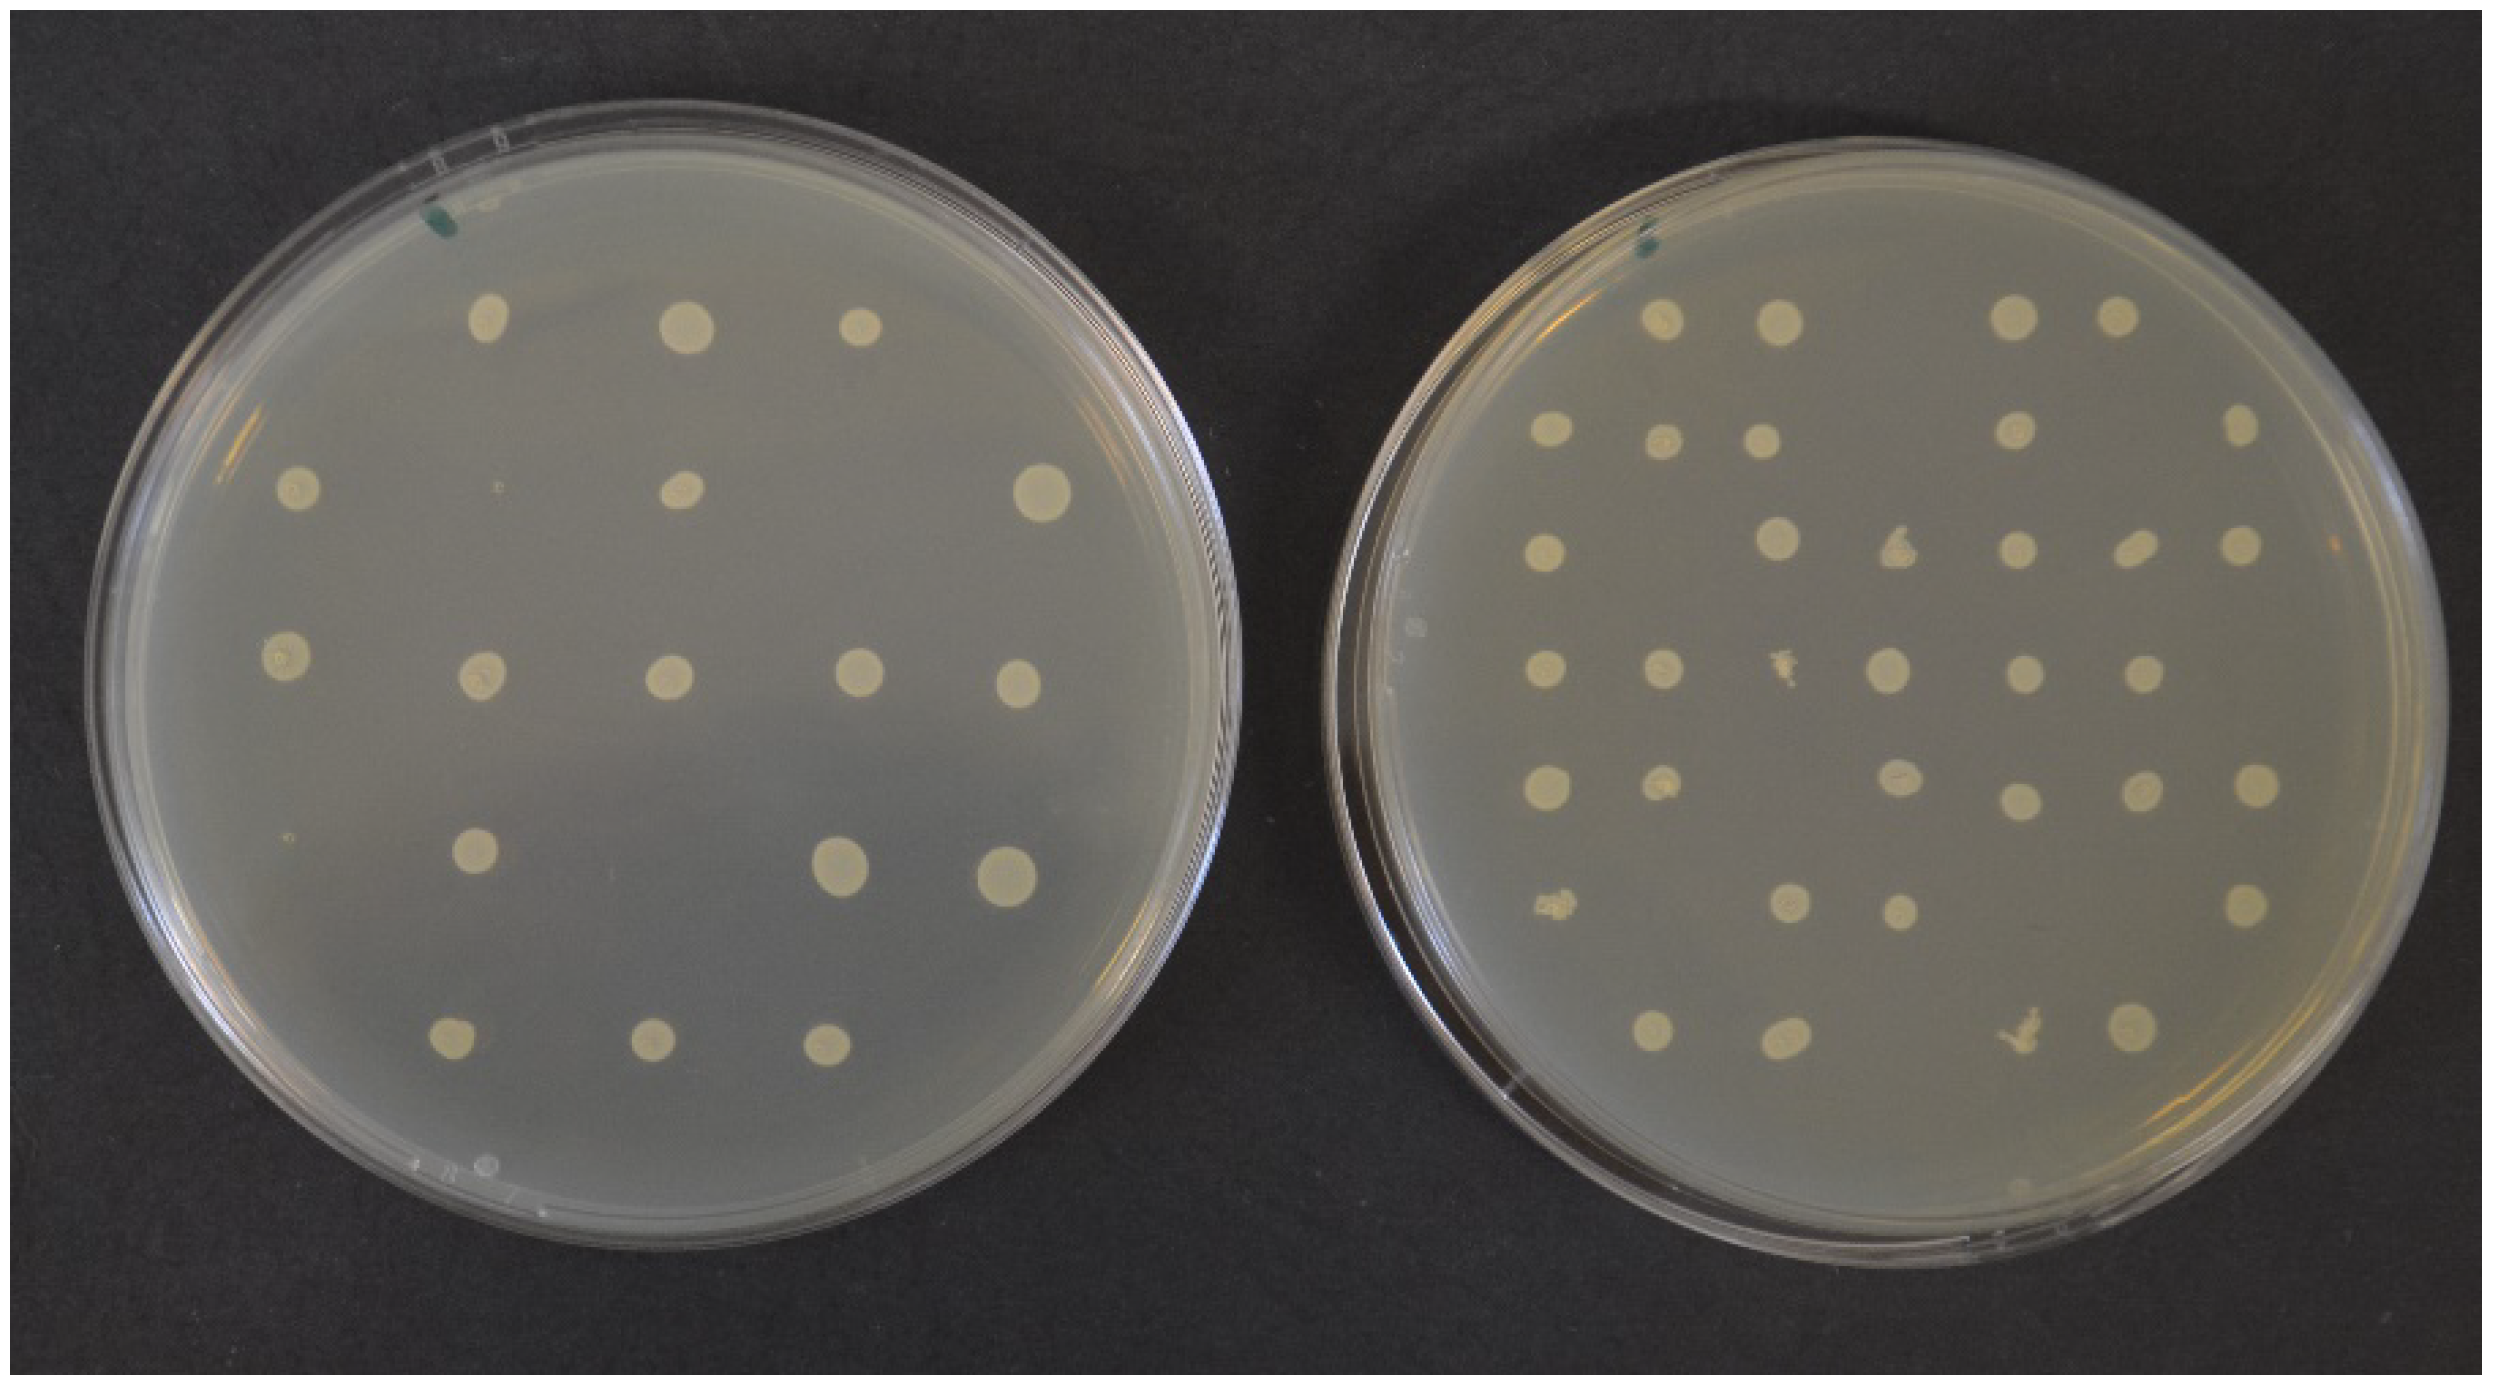
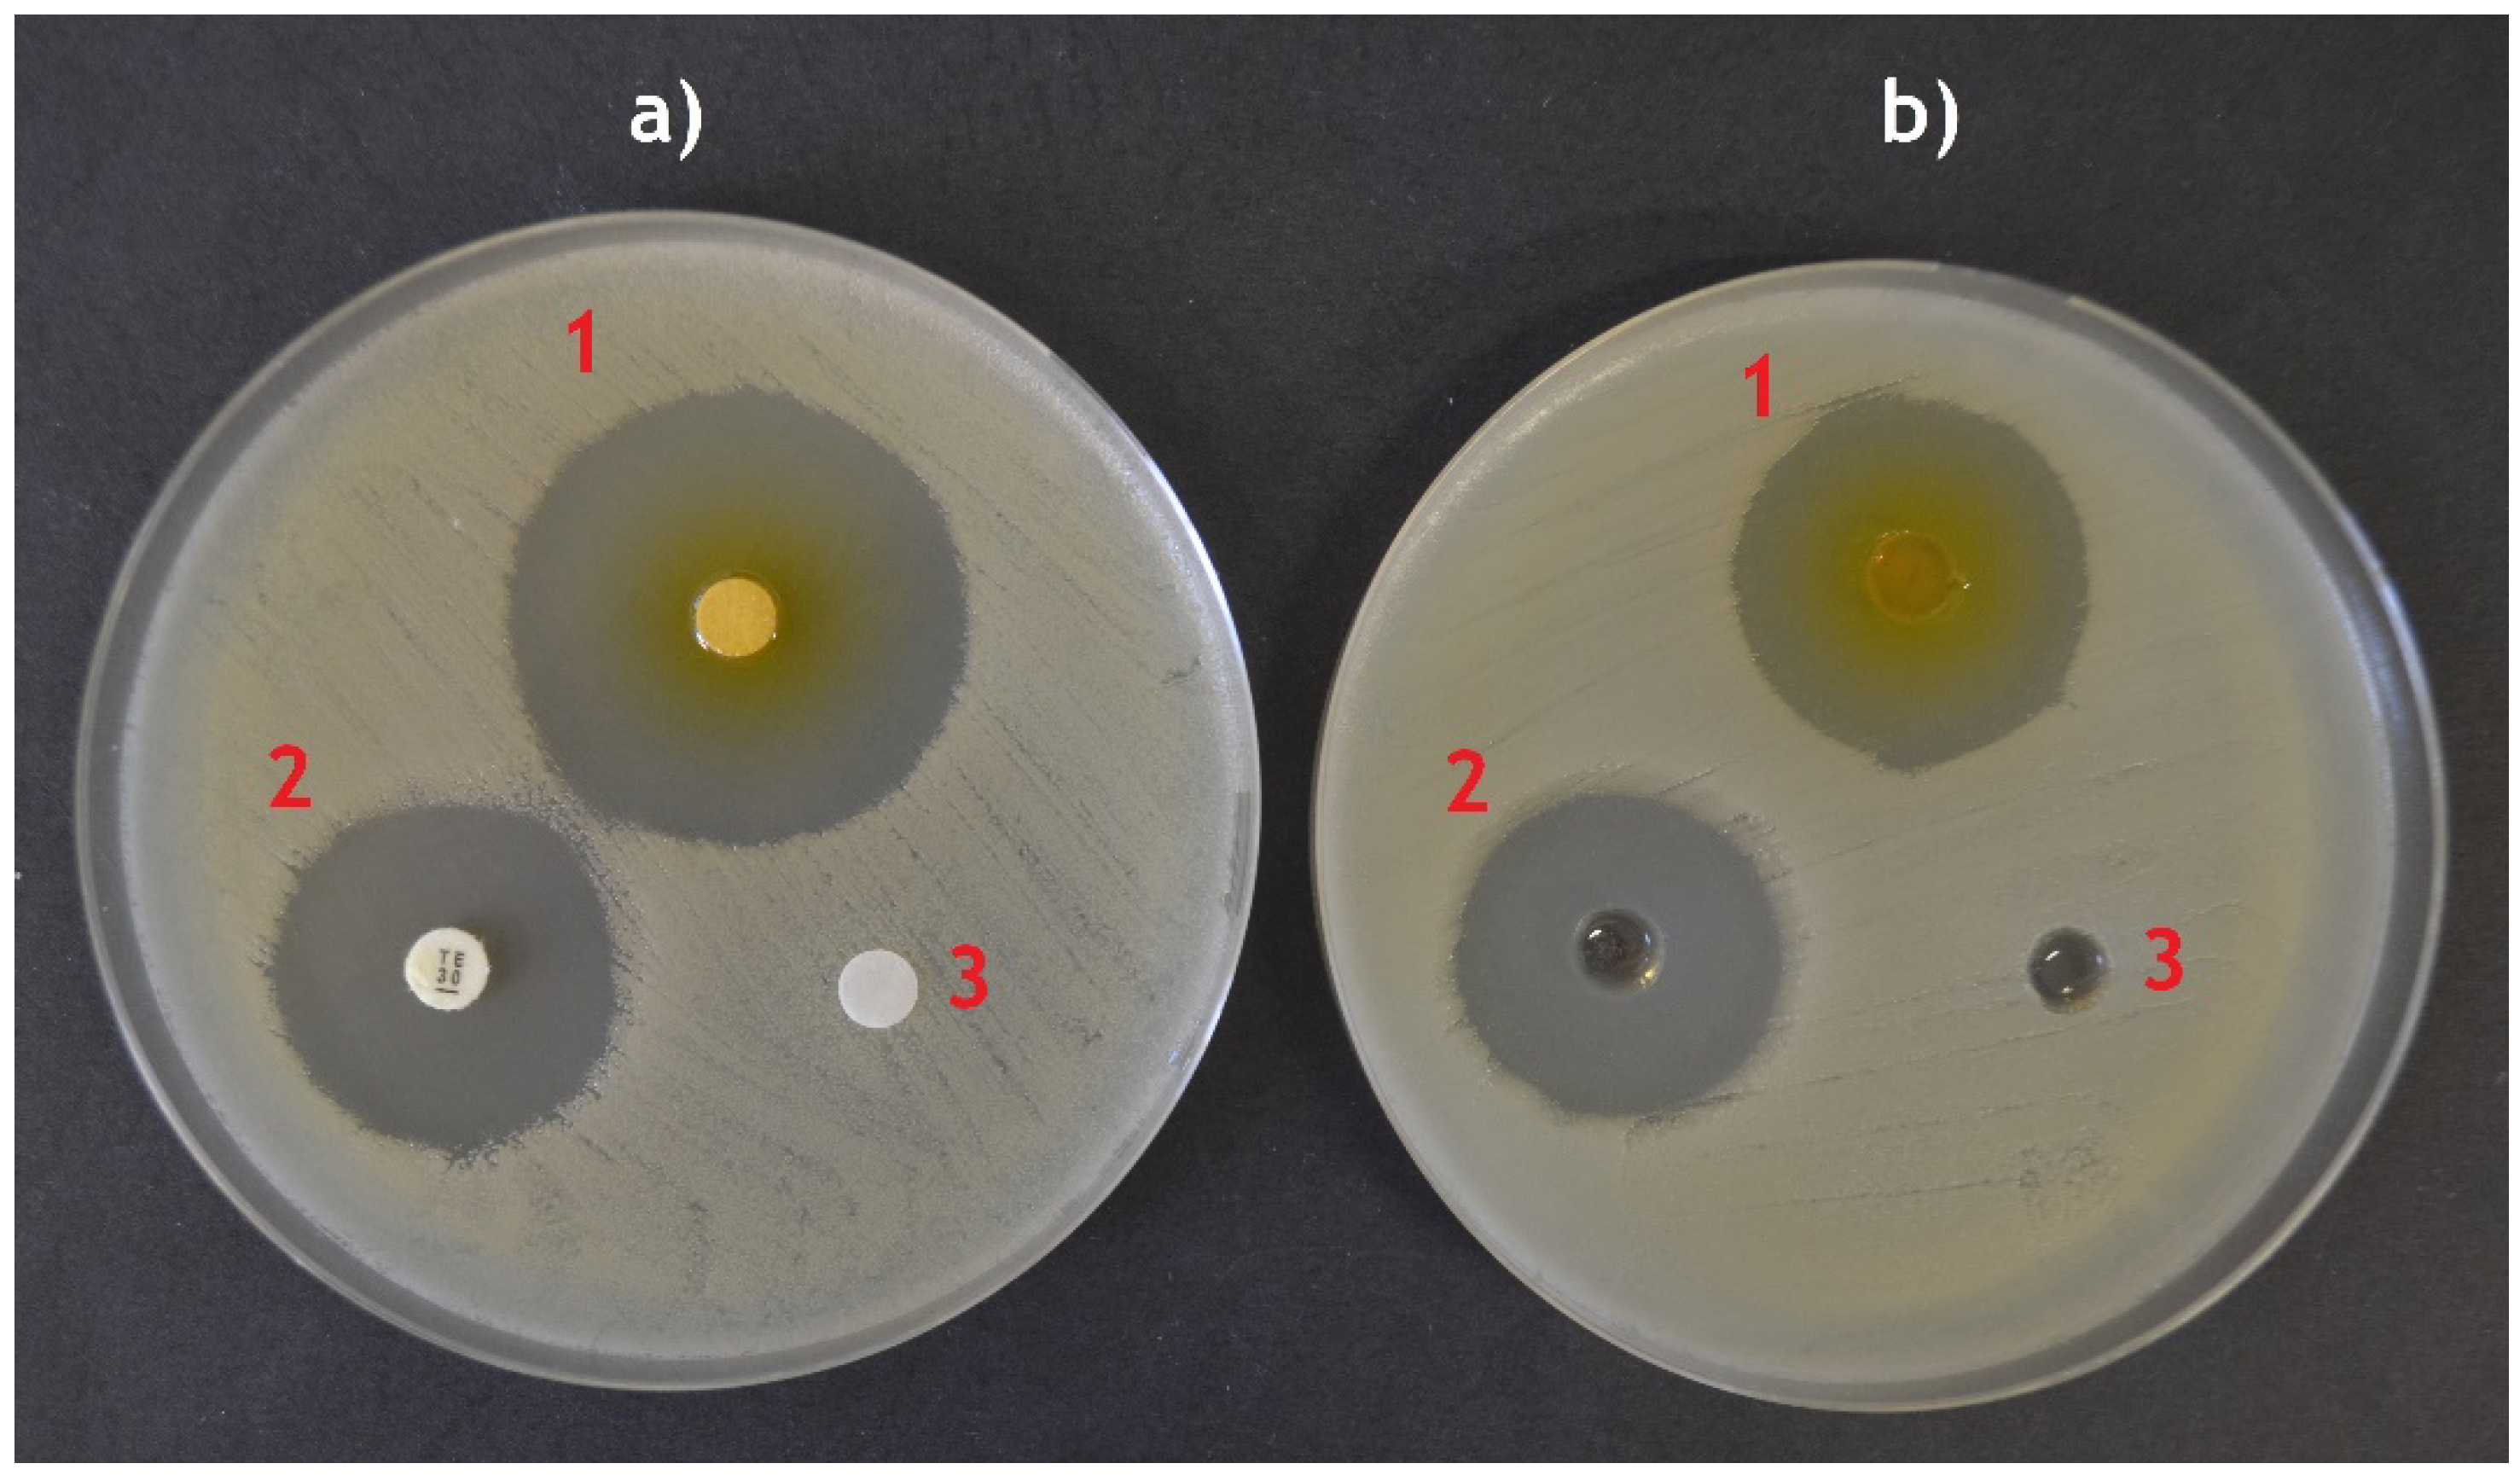

Submitted:
30 July 2024
Posted:
31 July 2024
You are already at the latest version
Abstract
Keywords:
1. Introduction
2. Determination of Minimum Inhibitory Concentration (MIC)
2.1. Broth Dilution Method
2.1.1. Inoculum Density
2.1.2. Type of Broth
2.1.3. Stabilization of the oil-in-Water Mixture
2.1.4. Endpoint Determination
2.1.5. Units of MIC
2.2. Agar Dilution Method
3. Determination of Minimum Bactericidal Concentration (MBC)
4. Kinetic Studies
5. Agar Diffusion Methods
5.1. Disc Diffusion Method
5.2. Well-Diffusion Method
6. Antimicrobial Activity in Vapor Phase
7. Antimicrobial Activity against Biofilm Formation
8. Other methods Engaged in Testing of EOs’ Antimicrobial Activities
9. Conclusions and PROSPECT
- Chemical composition of the tested EO/EOs should be always made available, since there’s a great variability among EOs of the same botanical origin. Note that many journals have already made that mandatory.
- It is highly recommended to use multiple assays, especially when agar diffusion method is engaged – this method is useful for preliminary studies, but should not stand alone as the only method of investigation.
- The assays need to be standardized as much as possible at least in the most important parameters. CLSI guidelines can be recommended for some parameters such as media, media preparation, inoculum size and quality control. For the disc diffusion method, a disc size of 6 mm soaked with 10 μL of EO is recommended. For broth dilution, MHB with 0.15% of agar for better dispersion of EO seems to be the most fitting medium, as there’s no doubt about its non-toxicity. Use of solvents such as ethanol or DMSO should be further considered and evaluated. If used, the maximum concentration should be stated and tested for toxicity especially when fastidious bacteria are to be tested.
- MIC should be reported in standardized units such as mg or μg/mL.
- All tests should be performed in triplicate.
Funding
Conflicts of Interest
References
- Franz, C; Novak, J. Sources of Essential Oils. In Handbook of Essential Oils: Science, Technology, and Applications, 3rd ed.; Baser, K.H.C., Buchbauer, G., Eds.; CRC Press: Boca Raton, FL, USA, 2020; pp. 41–84. [Google Scholar]
- Ribeiro-Santos, R; Andrade, M; Sanches-Silva, A; de Melo, N. R. Essential Oils for Food Application: Natural Substances with Established Biological Activities. Food Bioproc. Tech. 2018, 11, 43–71. [Google Scholar] [CrossRef]
- Hyldgaard, M; Mygind, T; Meyer, R. L. Essential Oils in Food Preservation: Mode of Action, Synergies, and Interactions with Food Matrix Components. Front. Microbiol. 2012, 3, 12. [Google Scholar]
- de Sousa, D.P.; Damasceno, R.O.S.; Amorati, R.; Elshabrawy, H.A.; de Castro, R.D.; Bezerra, D.P.; Nunes, V.R.V.; Gomes, R.C.; Lima, T.C. Essential Oils: Chemistry and Pharmacological Activities. Biomolecules 2023, 13, 1144. [Google Scholar] [CrossRef] [PubMed]
- Amiri, A.; Mottaghipisheh, J.; Jamshidi-Kia, F.; Saeidi, K.; Vitalini, S.; Iriti, M. Antimicrobial Potencies of Major Functional Foods’ Essential Oils in Liquid and Vapor Phases: A Short Review. Appl. Sci. 2020, 10, 8103. [Google Scholar] [CrossRef]
- Reyes-Jurado, F.; Franco-Vega, A.; Ramirez-Corona, N.; Palou, E.; López-Malo, A. Essential Oils: Antimicrobial Activities, Extraction Methods, and Their Modeling. Food Eng. Rev. 2015, 7, 275–297. [Google Scholar] [CrossRef]
- Masyita, A.; Mustika Sari, R.; Dwi Astuti, A.; Yasir, B.; Rahma Rumata, N.; Emran, T.B.; Nainu, F.; Simal-Gandara, J. Terpenes and Terpenoids as Main Bioactive Compounds of Essential Oils, Their Roles in Human Health and Potential Application as Natural Food Preservatives. Food Chem. X 2022, 13, 100217. [Google Scholar] [CrossRef] [PubMed]
- Burt, S. Essential Oils: Their Antibacterial Properties and Potential Applications in Foods – A Review. Int. J. Food Microbiol. 2004, 94, 223–253. [Google Scholar] [CrossRef]
- Ramsey, J.T.; Shropshire, B.C.; Nagy, T.R.; Chambers, K.D.; Li, Y.; Korach, K.S. Essential Oils and Health. Yale J. Biol. Med. 2020, 93, 291–305. [Google Scholar]
- Baser, K.H.C.; Franz, C. Essential Oils Used in Veterinary Medicine. In Handbook of Essential Oils: Science, Technology, and Applications, 3rd ed.; Baser, K.H.C., Buchbauer, G., Eds.; CRC Press: Boca Raton, USA, 2020; pp. 919–932. [Google Scholar]
- Guzmán, E.; Lucia, A. Essential Oils and Their Individual Components in Cosmetic Products. Cosmetics 2021, 8, 114. [Google Scholar] [CrossRef]
- Nahas, R.I. Natural antioxidants as food and beverage ingredients. In Natural Food Additives, Ingredients and Flavourings; Baines, D., Seal, R., Eds.; Woodhead Publishing: Cambridge, UK, 2012; pp. 100–126. [Google Scholar]
- Delves-Broughton, J. Natural antimicrobials as additives and ingredients for the preservation of foods and beverages. In Natural Food Additives, Ingredients and Flavourings; Baines, D., Seal, R., Eds.; Woodhead Publishing: Cambridge, UK, 2012; pp. 127–161. [Google Scholar]
- Rowe, D.J. Natural aroma chemicals for use in foods and beverages. In Natural Food Additives, Ingredients and Flavourings; Baines, D., Seal, R., Eds.; Woodhead Publishing: Cambridge, UK, 2012; pp. 212–230. [Google Scholar]
- Catani, L.; Grassi, E.; di Montanara, A.C.; Guidi, L.; Sandulli, R.; Manachini, B.; Semprucci, F. Essential Oils and Their Applications in Agriculture and Agricultural Products: A Literature Analysis through VOSviewer. Biocatal. Agric. Biotechnol. 2022, 45, 102502. [Google Scholar] [CrossRef]
- Calo, J.R.; Crandall, P.G.; O'Bryan, C.A.; Ricke, S.C. Essential Oils as Antimicrobials in Food Systems – A Review. Food Control 2015, 54, 111–119. [Google Scholar] [CrossRef]
- WHO. Global Antimicrobial Resistance Surveillance System: Manual for Early Implementation; World Health Organization: Geneva, Switzerland, 2015; Available online: https://apps.who.int/iris/handle/10665/188783 (accessed on 25/05/2024).
- Othman, M.; Loh, H.S.; Wiart, C.; Khoo, T.J.; Lim, K.H.; Ting, K.N. Optimal Methods for Evaluating Antimicrobial Activities from Plant Extracts. J. Microbiol. Methods 2011, 84, 161–166. [Google Scholar] [CrossRef] [PubMed]
- Balouiri, M.; Sadiki, M.; Ibnsouda, S.K. Methods for In Vitro Evaluating Antimicrobial Activity: A Review. J. Pharm. Anal. 2016, 6, 71–79. [Google Scholar] [CrossRef] [PubMed]
- Van de Vel, E.; Sampers, I.; Raes, K. A Review on Influencing Factors on the Minimum Inhibitory Concentration of Essential Oils. Crit. Rev. Food Sci. Nutr. 2019, 59, 357–378. [Google Scholar] [CrossRef] [PubMed]
- Rao, J.; Chen, B.; McClements, D. J. Improving the Efficacy of Essential Oils as Antimicrobials in Foods: Mechanisms of Action. Annu. Rev. Food Sci. Technol. 2019, 10, 365–387. [Google Scholar] [CrossRef] [PubMed]
- Mihajilov-Krstev, T.; Radnovic, D.; Kitic, D.; Stojanovic-Radic, Z.; Zlatkovic, B. Antimicrobial Activity of Satureja hortensis L. Essential Oil Against Pathogenic Microbial Strains. Biotechnol. Biotechnol. Equip. 2009, 23, 1492–1496. [Google Scholar] [CrossRef]
- Hussain, A. I.; Anwar, F.; Nigam, P. S.; Sarker, S. D.; Moore, J. E.; Rao, J. R.; Mazumdar, A. Antibacterial Activity of Some Lamiaceae Essential Oils Using Resazurin as an Indicator of Cell Growth. LWT-Food Sci. Technol. 2011, 44, 1199–1206. [Google Scholar] [CrossRef]
- Jadhav, S.; Shah, R.; Bhave, M.; Palombo, E. A. Inhibitory Activity of Yarrow Essential Oil on Listeria Planktonic Cells and Biofilms. Food Control 2013, 29, 125–130. [Google Scholar] [CrossRef]
- Miladinović, D.L.; Ilić, B.S.; Mihajilov-Krstev, T.M.; Nikolić, D.M.; Cvetković, O.G.; Marković, M.S.; Miladinović, L.C. Antibacterial Activity of the Essential Oil of Heracleum sibiricum. Nat. Prod. Commun. 2013, 8, 1309–1311. [Google Scholar] [CrossRef]
- Bazargani, M.M.; Rohloff, J. Antibiofilm Activity of Essential Oils and Plant Extracts Against Staphylococcus aureus and Escherichia coli Biofilms. Food Control 2016, 61, 156–164. [Google Scholar] [CrossRef]
- Puškárová, A.; Bučková, M.; Kraková, L.; Pangallo, D.; Kozics, K. The Antibacterial and Antifungal Activity of Six Essential Oils and Their Cyto/Genotoxicity to Human HEL 12469 Cells. Sci. Rep. 2017, 7, 8211. [Google Scholar] [CrossRef] [PubMed]
- Thielmann, J.; Muranyi, P.; Kazman, P. Screening Essential Oils for Their Antimicrobial Activities Against the Foodborne Pathogenic Bacteria Escherichia coli and Staphylococcus aureus. Heliyon 2019, 5, e01860. [Google Scholar] [CrossRef] [PubMed]
- Pellegrini, M.; Ricci, A.; Serio, A.; Chaves-López, C.; Mazzarrino, G.; D'Amato, S.; Lo Sterzo, C.; Paparella, A. Characterization of Essential Oils Obtained from Abruzzo Autochthonous Plants: Antioxidant and Antimicrobial Activities Assessment for Food Application. Foods 2018, 7, 19. [Google Scholar] [CrossRef] [PubMed]
- Houdkova, M.; Chaure, A.; Doskocil, I.; Havlik, J.; Kokoska, L. New Broth Macrodilution Volatilization Method for Antibacterial Susceptibility Testing of Volatile Agents and Evaluation of Their Toxicity Using Modified MTT Assay In Vitro. Molecules 2021, 26, 4179. [Google Scholar] [CrossRef] [PubMed]
- Hulankova, R. Higher Resistance of Yersinia enterocolitica in Comparison to Yersinia pseudotuberculosis to Antibiotics and Cinnamon, Oregano and Thyme Essential Oils. Pathogens 2022, 11, 1456. [Google Scholar] [CrossRef] [PubMed]
- Ostrosky, E.A.; Mizumoto, M.K.; Lima, M.E.L.; Kaneko, T.M.; Nishikawa, S.O.; Freitas, B.R. Methods for Evaluation of the Antimicrobial Activity and Determination of Minimum Inhibitory Concentration (MIC) of Plant Extracts. Rev. Bras. Farmacogn. 2008, 18, 301–307. [Google Scholar] [CrossRef]
- Wiegand, I.; Hilpert, K.; Hancock, R.E.W. Agar and Broth Dilution Methods to Determine the Minimal Inhibitory Concentration (MIC) of Antimicrobial Substances. Nat. Protoc. 2008, 3, 163–175. [Google Scholar] [CrossRef] [PubMed]
- CLSI. Methods for Dilution Antimicrobial Susceptibility Tests for Bacteria That Grow Aerobically, W: M07, 11th ed. Clinical and Laboratory Standards Institute, 2018; M07.
- Zhao, A.; Zhang, Y.; Li, F.; Chen, L.; Huang, X. Analysis of the Antibacterial Properties of Compound Essential Oil and the Main Antibacterial Components of Unilateral Essential Oils. Molecules 2023, 28, 6304. [Google Scholar] [CrossRef]
- Cervenka, L.; Peskova, I.; Pejchalova, M.; Vytrasova, J. Inhibition of Arcobacter butzleri, Arcobacter cryaerophilus, and Arcobacter skirrowii by Plant Oil Aromatics. J. Food Prot. 2008, 71, 165–169. [Google Scholar] [CrossRef]
- Donaldson, J.R.; Warner, S.L.; Cates, R.G.; Young, D.G. Assessment of Antimicrobial Activity of Fourteen Essential Oils When Using Dilution and Diffusion Methods. Pharm. Biol. 2005, 43, 687–695. [Google Scholar] [CrossRef]
- Sakkas, H.; Economou, V.; Gousia, P.; Bozidis, P.; Sakkas, V.A.; Petsios, S.; Mpekoulis, G.; Ilia, A.; Papadopoulou, C. Antibacterial Efficacy of Commercially Available Essential Oils Tested Against Drug-Resistant Gram-Positive Pathogens. Appl. Sci. 2018, 8, 2201. [Google Scholar] [CrossRef]
- de Azeredo, G.A.; Stamford, T.L.M.; Nunes, P.C.; Neto, N.J.G.; de Oliveira, M.E.C.; de Souza, E.L. Combined Application of Essential Oils from Origanum vulgare L. and Rosmarinus officinalis L. to Inhibit Bacteria and Autochthonous Microflora Associated with Minimally Processed Vegetables. Food Res. Int. 2011, 44, 1541–1548. [Google Scholar] [CrossRef]
- Porter, J.A.; Monu, E.A. Evaluating the Antimicrobial Efficacy of White Mustard Essential Oil Alone and in Combination with Thymol and Carvacrol Against Salmonella. J. Food Prot. 2019, 82, 2038–2043. [Google Scholar] [CrossRef] [PubMed]
- Kavanagh, A.; Ramu, S.; Gong, Y.; Cooper, M.A.; Blaskovich, M.A.T. Effects of Microplate Type and Broth Additives on Microdilution MIC Susceptibility Assays. Antimicrob. Agents Chemother. 2019, 63, e01760–18. [Google Scholar] [CrossRef] [PubMed]
- ISO. ISO 20776-1:2019 Susceptibility testing of infectious agents and evaluation of performance of antimicrobial susceptibility test devices Part 1: Broth micro-dilution reference method for testing the in vitro activity of antimicrobial agents against rapidly growing aerobic bacteria involved in infectious diseases. G: Organisation for Standardisation, 2019.
- Vanegas, D.; Abril-Novillo, A.; Khachatryan, A.; Jerves-Andrade, L.; Peñaherrera, E.; Cuzco, N.; Wilches, I.; Calle, J.; León-Tamariz, F. Validation of a Method of Broth Microdilution for the Determination of Antibacterial Activity of Essential Oils. BMC Res. Notes 2021, 14, 439. [Google Scholar] [CrossRef] [PubMed]
- Seow, Y.X.; Yeo, C.R.; Chung, H.L.; Yuk, H.G. Plant Essential Oils as Active Antimicrobial Agents. Crit. Rev. Food Sci. Nutr. 2014, 54, 625–644. [Google Scholar] [CrossRef] [PubMed]
- Klančnik, A.; Piskernik, S.; Jeršek, B.; Smole Možina, S. Evaluation of Diffusion and Dilution Methods to Determine the Antibacterial Activity of Plant Extracts. J. Microbiol. Methods 2010, 81, 121–126. [Google Scholar] [CrossRef]
- Kavanaugh, N.L.; Ribbeck, K. Selected Antimicrobial Essential Oils Eradicate Pseudomonas spp. and Staphylococcus aureus Biofilms. Appl. Environ. Microbiol. 2012, 78, 4057–4061. [Google Scholar] [CrossRef]
- Boukhira, S.; Balouiri, M.; Bousta, F.; Moularat, S.; Taleb, M.S.; Bousta, D. Antimicrobial Activities of Essential Oil of Five Plant Species from Morocco Against Some Microbial Strains. Int. J. Pharmacogn. Pharm. Res. 2016, 8, 1901–1906. [Google Scholar]
- Park, J.W.; Wendt, M.; Heo, G.J. Antimicrobial Activity of Essential Oil of Eucalyptus globulus Against Fish Pathogenic Bacteria. Lab Anim. Res. 2016, 32, 87–90. [Google Scholar] [CrossRef]
- Alexopoulos, A.; Plessas, S.; Kimbaris, A.; Varvatou, M.; Mantzourani, I.; Fournomiti, M. Mode of Antimicrobial Action of Origanum vulgare Essential Oil Against Clinical Pathogens. Curr. Res. Nutr. Food Sci. 2017, 5, 109–115. [Google Scholar] [CrossRef]
- Sadiki, F.Z.; El Idrissi, M.; Sbiti, M.; Lemrhari, A.; Trifan, A.; Cioanca, O.; Postu, P.A.; Hritcu, L. Chemical Composition and Antibacterial Activity of Essential Oil of Tetraclinis articulata (Vahl) Masters Branches of Eastern Morocco. Chem. Biol. Technol. Agric. 2018, 5, 24. [Google Scholar] [CrossRef]
- Gonçalves, G.M.S.; Barros, P.P.; Silva, G.H.; Fedes, G.R. The Essential Oil of Curcuma longa Rhizomes as an Antimicrobial and Its Composition by CG-MS. Rev. Ciênc. Med. 2019, 28, 1–10. [Google Scholar] [CrossRef]
- Rathore, S.; Mukhia, S.; Kapoor, S.; Bhatt, V.; Kumar, R.; Kumar, R. Seasonal Variability in Essential Oil Composition and Biological Activity of Rosmarinus officinalis L. Accessions in the Western Himalaya. Sci. Rep. 2022, 12, 3305. [Google Scholar] [CrossRef] [PubMed]
- Van, N.T.B.; Vi, O.T.; Yen, N.T.P.; Nhung, N.T.; Cuong, N.V.; Kiet, B.T.; Hoang, N.V.; Hien, V.B.; Thwaites, G.; Campbell, J.; Choisy, M.; Carrique-Mas, J. Minimum Inhibitory Concentrations of Commercial Essential Oils Against Common Chicken Pathogenic Bacteria and Their Relationship with Antibiotic Resistance. J. Appl. Microbiol. 2022, 132, 1025–1035. [Google Scholar] [CrossRef] [PubMed]
- Abdelatti, M.A.I.; Abd El-Aziz, N.K.; El-Naenaeey, E.Y.M.; Ammar, A.M.; Alharbi, N.K.; Alharthi, A.; Zakai, S.A.; Abdelkhalek, A. Antibacterial and Anti-Efflux Activities of Cinnamon Essential Oil Against Pan and Extensive Drug-Resistant Pseudomonas aeruginosa Isolated from Human and Animal Sources. Antibiotics 2023, 12, 1514. [Google Scholar] [CrossRef]
- Chen, S.; Li, Z.; Gu, Z.; Ban, X.; Hong, Y.; Cheng, L.; Li, C. A New Micro-Agar Dilution Method to Determine the Minimum Inhibitory Concentration of Essential Oils Against Microorganisms. J. Microbiol. Methods 2023, 211, 106791. [Google Scholar] [CrossRef]
- Cui, Z.H.; He, H.L.; Wu, S.B.; Dong, C.L.; Lu, S.Y.; Shan, T.J.; Fang, L.X.; Liao, X.P.; Liu, Y.H.; Sun, J. Rapid Screening of Essential Oils as Substances Which Enhance Antibiotic Activity Using a Modified Well Diffusion Method. Antibiotics 2021, 10, 463. [Google Scholar] [CrossRef] [PubMed]
- EUCAST. Media Preparation for EUCAST Disk Diffusion Testing and for Determination of MIC Values by the Broth Microdilution Method, V: 6.0. European Committee on Antimicrobial Susceptibility Testing, 2020.
- Rota, C.; Carramiñana, J.J.; Burillo, J.; Herrera, A. In Vitro Antimicrobial Activity of Essential Oils from Aromatic Plants Against Selected Foodborne Pathogens. J. Food Prot. 2004, 67, 1252–1256. [Google Scholar] [CrossRef]
- Raeisi, M.; Tajik, H.; Yarahmadi, A.; Sanginabadi, S. Antimicrobial Effect of Cinnamon Essential Oil Against Escherichia coli and Staphylococcus aureus. Health Scope 2015, 4, e21808. [Google Scholar] [CrossRef]
- Knezevic, P.; Aleksic Sabo, V.; Simin, N.; Lesjak, M.; Mimica-Dukic, N. A Colorimetric Broth Microdilution Method for Assessment of Helicobacter pylori Sensitivity to Antimicrobial Agents. J. Pharm. Biomed. Anal. 2018, 152, 271–278. [Google Scholar] [CrossRef] [PubMed]
- Hsaine, S.; Charof, R.; Ounine, K. Evaluation of Antibacterial Activity of Essential Oil of Cinnamomum zeylanicum, Eugenia caryophyllata, and Rosmarinus officinalis Against Streptococcus oralis. Asian J. Pharm. Clin. Res. 2017, 10, 411–413. [Google Scholar] [CrossRef]
- Bouyahya, A.; Abrini, J.; Dakka, N.; Bakri, Y. Essential Oils of Origanum compactum Increase Membrane Permeability, Disturb Cell Membrane Integrity, and Suppress Quorum-Sensing Phenotype in Bacteria. J. Pharm. Anal. 2019, 9, 301–311. [Google Scholar] [CrossRef] [PubMed]
- Cazella, L.N.; Glamoclija, J.; Soković, M.; Gonçalves, J.E.; Linde, G.A.; Colauto, N.B.; Gazim, Z.C. Antimicrobial Activity of Essential Oil of Baccharis dracunculifolia DC (Asteraceae) Aerial Parts at Flowering Period. Front. Plant Sci. 2019, 10, 27. [Google Scholar] [CrossRef]
- Sateriale, D.; Forgione, G.; De Cristofaro, G.A.; Facchiano, S.; Boscaino, F.; Pagliuca, C.; Colicchio, R.; Salvatore, P.; Paolucci, M.; Pagliarulo, C. Towards Green Strategies of Food Security: Antibacterial Synergy of Essential Oils from Thymus vulgaris and Syzygium aromaticum to Inhibit Escherichia coli and Staphylococcus aureus Pathogenic Food Isolates. Microorganisms 2022, 10, 2446. [Google Scholar] [CrossRef] [PubMed]
- Cai, T.; Li, Z.; Guo, P.; Guo, J.; Wang, R.; Guo, D.; Yu, J.; Lü, X.; Xia, X.; Shi, C. Antimicrobial and Antibiofilm Efficacy and Mechanism of Oregano Essential Oil Against Shigella flexneri. Foodborne Pathog. Dis. 2023, 20, 209–221. [Google Scholar] [CrossRef] [PubMed]
- Iacovelli, F.; Romeo, A.; Lattanzio, P.; Ammendola, S.; Battistoni, A.; La Frazia, S.; Vindigni, G.; Unida, V.; Biocca, S.; Gaziano, R.; et al. Deciphering the Broad Antimicrobial Activity of Melaleuca alternifolia Tea Tree Oil by Combining Experimental and Computational Investigations. Int. J. Mol. Sci. 2023, 24, 12432. [Google Scholar] [CrossRef] [PubMed]
- de Barros, J.C.; da Conceição, M.L.; Neto, N.J.; da Costa, A.C.; de Souza, E.L. Combination of Origanum vulgare L. Essential Oil and Lactic Acid to Inhibit Staphylococcus aureus in Meat Broth and Meat Model. Braz. J. Microbiol. 2012, 43, 1120–1127. [Google Scholar] [CrossRef] [PubMed]
- Nagalakshmi, S.; Saranraj, P.; Sivasakthivelan, P. Determination of Minimum Inhibitory Concentration (MIC) and Percentage Bacterial Growth Inhibition of Essential Oils Against Gram Positive Bacterial Pathogens. J. Drug Deliv. Ther. 2019, 9, 33–35. [Google Scholar] [CrossRef]
- Liu, J.X.; Huang, D.F.; Hao, D.L.; Hu, Q.P. Chemical Composition, Antibacterial Activity of the Essential Oil from Roots of Radix aucklandiae Against Selected Food-Borne Pathogens. Adv. Biosci. Biotechnol. 2014, 5, 1043–1047. [Google Scholar] [CrossRef]
- Araby, E.; El-Tablawy, S.Y. Inhibitory Effects of Rosemary (Rosmarinus officinalis L.) Essential Oil on Pathogenicity of Irradiated and Non-Irradiated Pseudomonas aeruginosa. J. Photochem. Photobiol. B 2016, 159, 24–32. [Google Scholar] [CrossRef]
- Hulankova, R. The Influence of Liquid Medium Choice in Determination of Minimum Inhibitory Concentration of Essential Oils Against Pathogenic Bacteria. Antibiotics 2022, 11, 150. [Google Scholar] [CrossRef]
- Yalkowsky, S.H.; He, Y.; Jain, P. Handbook of Aqueous Solubility Data, 2nd ed.; CRC Press: Boca Raton, USA, 2010. [Google Scholar]
- Ilić, B.S.; Kocić, B.D.; Cirić, V.M.; Ćvetković, O.G.; Miladinović, D.L. An In Vitro Synergistic Interaction of Combinations of Thymus glabrescens Essential Oil and Its Main Constituents with Chloramphenicol. Sci. World J. 2014, 2014, 826219. [Google Scholar] [CrossRef]
- dal Pozzo, M.; Silva Loreto, E.; Flores Santurio, D.; Hartz Alves, S.; Rossatto, L.; Castagna de Vargas, A.; Viegas, J.; Matiuzzi da Costa, M. Antibacterial Activity of Essential Oil of Cinnamon and Trans-Cinnamaldehyde Against Staphylococcus spp. Isolated from Clinical Mastitis of Cattle and Goats. Acta Sci. Vet. 2012, 40, 1–5. [Google Scholar]
- Wadhwani, T.; Desai, K.; Patel, D.; Lawani, D.; Bahaley, P.; Joshi, P.; Vijay, K. Effect of Various Solvents on Bacterial Growth in Context of Determining MIC of Various Antimicrobials. Internet J. Microbiol. 2018, 7, 1–6. [Google Scholar]
- Tadtong, S.; Suppawat, S.; Tintawee, A.; Saramas, P.; Jareonvong, S.; Hongratanaworakit, T. Antimicrobial Activity of Blended Essential Oil Preparation. Nat. Prod. Commun. 2012, 7, 1401–1404. [Google Scholar] [CrossRef] [PubMed]
- Alitonou, G.A.; Sessou, P.; Tchobo, P.F.; Noudogbessi, J.P.; Avlessi, F.; Yehouenou, B.; Menut, C.; Villeneuve, P.; Sohounhloue, D.C.K. Chemical Composition and Biological Activities of Essential Oils of Chenopodium ambrosioides L. Collected in Two Areas of Benin. Int. J. Biosci. 2012, 2, 58–66. [Google Scholar]
- Nielsen, C.K.; Kjems, J.; Mygind, T.; Snabe, T.; Meyer, R.L. Effects of Tween 80 on Growth and Biofilm Formation in Laboratory Media. Front. Microbiol. 2016, 7, 1878. [Google Scholar] [CrossRef]
- Tovidé, S.N.; Adeoti, K.; Yèhouénou, B.; Dahouénon-Ahoussi, E.; Baba-Moussa, F.; Toukourou, F. Antimicrobial and Physico-Chemical Effects of Essential Oil on Fermented Milk During Preservation. J. Appl. Biosci. 2016, 99, 9469–9477. [Google Scholar]
- da Silva, B.D.; do Rosário, D.K.A.; Neto, L.T.; Lelis, C.A.; Conte-Junior, C.A. Antioxidant, Antibacterial and Antibiofilm Activity of Nanoemulsion-Based Natural Compound Delivery Systems Compared with Non-Nanoemulsified Versions. Foods 2023, 12, 1901. [Google Scholar] [CrossRef]
- Weseler, A.; Geiss, H.K.; Saller, R.; Reichling, J. A Novel Colorimetric Broth Microdilution Method to Determine the Minimum Inhibitory Concentration (MIC) of Antibiotics and Essential Oils Against Helicobacter pylori. Pharmazie 2005, 60, 498–502. [Google Scholar] [PubMed]
- Anwer, M.K.; Jamil, S.; Ibnouf, E.O.; Shakeel, F. Enhanced Antibacterial Effects of Clove Essential Oil by Nanoemulsion. J. Oleo Sci. 2014, 63, 347–354. [Google Scholar] [CrossRef] [PubMed]
- Pimple, V.V.; Kulkarni, A.S.; Patil, S.P.; Dhoble, S.J. Plant Essential Oils Based Nanoemulsion Formulations and Its Antibacterial Effect on Some Pathogens. Int. J. Innov. Technol. Explor. Eng. 2019, 9, 4800–4808. [Google Scholar] [CrossRef]
- Remmal, A.; Bouchikhi, T.; Tantaoui-Elaraki, A.; Ettayebi, M. Inhibition of Antibacterial Activity of Essential Oils by Tween 80 and Ethanol in Liquid Medium. J. Pharm. Belg. 1993, 48, 352–356. [Google Scholar] [PubMed]
- Mann, C.M.; Markham, J.L. A New Method for Determining the Minimum Inhibitory Concentration of Essential Oils. J. Appl. Microbiol. 1998, 84, 538–544. [Google Scholar] [CrossRef] [PubMed]
- Sarker, S.D.; Nahar, L.; Kumarasamy, Y. Microtitre Plate-Based Antibacterial Assay Incorporating Resazurin as an Indicator of Cell Growth, and Its Application in the In Vitro Antibacterial Screening of Phytochemicals. Methods 2007, 42, 321–324. [Google Scholar] [CrossRef]
- Braissant, O.; Astasov-Frauenhoffer, M.; Waltimo, T.; Bonkat, G. A Review of Methods to Determine Viability, Vitality, and Metabolic Rates in Microbiology. Front. Microbiol. 2020, 11, 547458. [Google Scholar] [CrossRef]
- Eloff, J.N. Avoiding Pitfalls in Determining Antimicrobial Activity of Plant Extracts and Publishing the Results. BMC Complement. Altern. Med. 2019, 19, 106. [Google Scholar] [CrossRef] [PubMed]
- Zarai, Z.; Ben Chobba, I.; Ben Mansour, R.; Békir, A.; Gharsallah, N.; Kadri, A. Essential Oil of the Leaves of Ricinus communis L.: In Vitro Cytotoxicity and Antimicrobial Properties. Lipids Health Dis. 2012, 11, 102. [Google Scholar] [CrossRef]
- Yèhouenou, B.; Wotto, D.V.; Sessou, P.; Noudogbessi, J.P.; Sohounhloue, D.C.K. Chemical Study and Antimicrobial Activities of Volatile Extracts from Fresh Leaves of Crassocephalum rubens (Juss and Jack.) S. Moore Against Food Borne Pathogens. Sci. Study Res.: Chem. Chem. Eng. Biotechnol. Food Ind. 2010, 11, 343–351. [Google Scholar]
- Szweda, P.; Zalewska, M.; Pilch, J.; Kot, B.; Milewski, S. Essential Oils as Potential Anti-Staphylococcal Agents. Acta Vet. 2018, 68, 95–107. [Google Scholar]
- Kačániová, M.; Vukic, M.; Vukovic, N.L.; Čmiková, N.; Verešová, A.; Schwarzová, M.; Babošová, M.; Porhajašová, J.I.; Kluz, M.; Waszkiewicz-Robak, B.; Ben Hsouna, A.; Ben Saad, R.; Garzoli, S. An In-Depth Study on the Chemical Composition and Biological Effects of Pelargonium graveolens Essential Oil. Foods 2024, 13, 33. [Google Scholar] [CrossRef]
- d’Acampora Zellner, B.; Dugo, P.; Dugo, G.; Mondello, L. Analysis of Essential Oils. In Handbook of Essential Oils: Science, Technology, and Applications, 3rd ed.; Baser, K.H.C., Buchbauer, G., Eds.; CRC Press: Boca Raton, USA, 2020; pp. 151–183. [Google Scholar]
- Ríos, J.L. Essential Oils: What They Are and How the Terms Are Used and Defined. In Essential Oils in Food Preservation, Flavor and Safety, 1st ed.; Preedy, V.R., Ed.; Academic Press: London, UK, 2016; pp. 3–10. [Google Scholar]
- Golus, J.; Sawicki, R.; Widelski, J.; Ginalska, G. The Agar Microdilution Method - A New Method for Antimicrobial Susceptibility Testing for Essential Oils and Plant Extracts. J. Appl. Microbiol. 2016, 121, 1291–1299. [Google Scholar] [CrossRef] [PubMed]
- Fei, P.; Xu, Y.; Zhao, S.; Gong, S.; Guo, L. Olive Oil Polyphenol Extract Inhibits Vegetative Cells of Bacillus cereus Isolated from Raw Milk. J. Dairy Sci. 2019, 102, 3894–3902. [Google Scholar] [CrossRef]
- Liu, M.; Pan, Y.; Feng, M.; Guo, W.; Fan, X.; Feng, L.; Huang, J.; Cao, Y. Garlic Essential Oil in Water Nanoemulsion Prepared by High-Power Ultrasound: Properties, Stability, and Its Antibacterial Mechanism Against MRSA Isolated from Pork. Ultrason. Sonochem. 2022, 90, 106201. [Google Scholar] [CrossRef] [PubMed]
- López, E.I.C.; Balcázar, M.F.H.; Mendoza, J.M.R.; Ortiz, A.D.R.; Melo, M.T.O.; Parrales, R.S.; Delgado, T.H. Antimicrobial Activity of Essential Oil of Zingiber officinale Roscoe (Zingiberaceae). Am. J. Plant Sci. 2017, 8, 1511–1524. [Google Scholar] [CrossRef]
- Nikolić, I.; Chua, E.G.; Tay, A.C.Y.; Kostrešević, A.; Pavlović, B.; Jončić Savić, K. Savory, Oregano, and Thyme Essential Oil Mixture (HerbELICO®) Counteracts Helicobacter pylori. Molecules 2023, 28, 2138. [Google Scholar] [CrossRef] [PubMed]
- Ramezani, M.; Behravan, J.; Yazdinezhad, A. Chemical Composition and Antimicrobial Activity of the Volatile Oil of Artemisia khorassanica from Iran. Pharm. Biol. 2005, 42, 599–602. [Google Scholar] [CrossRef]
- Shi, C.; Song, K.; Zhang, X.; Sun, Y.; Sui, Y.; Chen, Y.; Jia, Z.; Sun, H.; Sun, Z.; Xia, X. Antimicrobial Activity and Possible Mechanism of Action of Citral Against Cronobacter sakazakii. PLoS One 2016, 11, e0159006. [Google Scholar] [CrossRef]
- Sun, Y.; Guo, D.; Hua, Z.; Sun, H.; Zheng, Z.; Xia, X.; Shi, C. Attenuation of Multiple Vibrio parahaemolyticus Virulence Factors by Citral. Front. Microbiol. 2019, 10, 894. [Google Scholar] [CrossRef]
- Prabuseenivasan, S.; Jayakumar, M.; Ignacimuthu, S. In Vitro Antibacterial Activity of Some Plant Essential Oils. BMC Complement Altern. Med. 2006, 6, 39. [Google Scholar] [CrossRef] [PubMed]
- Fraternale, D.; Genovese, S.; Ricci, D. Essential Oil Composition and Antimicrobial Activity of Aerial Parts and Ripe Fruits of Echinophora spinosa (Apiaceae) from Italy. Nat. Prod. Commun. 2013, 8, 527–530. [Google Scholar] [CrossRef] [PubMed]
- Selim, S. Antimicrobial Activity of Essential Oils Against Vancomycin-Resistant Enterococci (VRE) and Escherichia coli O157 in Feta Soft Cheese and Minced Beef Meat. Braz. J. Microbiol. 2011, 42, 187–196. [Google Scholar] [CrossRef] [PubMed]
- CLSI. Performance Standards for Antimicrobial Disk Susceptibility Tests, W: M02, 14th ed. Clinical and Laboratory Standards Institute, 2024; M02.
- Valgas, C.; de Souza, S.M.; Smânia, E.F.A.; Smânia, A. Screening Methods to Determine Antibacterial Activity of Natural Products. Braz. J. Microbiol. 2007, 38, 369–380. [Google Scholar] [CrossRef]
- Ponce, A.G.; Fritz, R.; Del Valle, C.; Roura, S.I. Antimicrobial Activity of Essential Oils on the Native Microflora of Organic Swiss Chard. Lebensm. Wiss. Technol. 2003, 36, 679–684. [Google Scholar] [CrossRef]
- Rota, M.C.; Herrera, A.; Martínez, R.M.; Sotomayor, J.A.; Jordán, M.J. Antimicrobial Activity and Chemical Composition of Thymus vulgaris, Thymus zygis, and Thymus hyemalis Essential Oils. Food Control 2008, 19, 681–687. [Google Scholar] [CrossRef]
- Ignatiuk, K.; Dzikon, E.; Hagdej, B.; Slotwinska, W.; Malm, M.; Ossowski, M.; Kasela, M. Comparison of Disc-Diffusion and Disc-Volatilization Assays for Determining the Antimicrobial Activity of Thymus vulgaris L. Essential Oil. Curr. Issues Pharm. Med. Sci. 2023, 36, 158–162. [Google Scholar] [CrossRef]
- Busatta, C.; Vidal, R.S.; Popiolski, A.S.; Mossi, A.J.; Dariva, C.; Rodrigues, M.R.; Corazza, F.C.; Corazza, M.L.; Vladimir Oliveira, J.; Cansian, R.L. Application of Origanum majorana L. Essential Oil as an Antimicrobial Agent in Sausage. Food Microbiol. 2008, 25, 207–211. [Google Scholar] [CrossRef]
- Houdkova, M.; Kokoska, L. Volatile Antimicrobial Agents and In Vitro Methods for Evaluating Their Activity in the Vapour Phase: A Review. Planta Med. 2020, 86, 822–857. [Google Scholar] [CrossRef]
- Laird, K.; Phillips, C. Vapour Phase: A Potential Future Use for Essential Oils as Antimicrobials? Lett. Appl. Microbiol. 2012, 54, 169–174. [Google Scholar] [CrossRef]
- López, P.; Sánchez, C.; Batlle, R.; Nerín, C. Solid- and Vapour-Phase Antimicrobial Activities of Six Essential Oils: Susceptibility of Selected Foodborne Bacterial and Fungal Strains. J. Agric. Food Chem. 2005, 53, 6939–6946. [Google Scholar] [CrossRef]
- Ács, K.; Balázs, V.L.; Kocsis, B.; Bencsik, T.; Böszörményi, A.; Horváth, G. Antibacterial Activity Evaluation of Selected Essential Oils in Liquid and Vapor Phase on Respiratory Tract Pathogens. BMC Complement Altern. Med. 2018, 18, 227. [Google Scholar] [CrossRef] [PubMed]
- Kloucek, P.; Smid, J.; Frankova, A.; Kokoska, L.; Valterova, I.; Pavela, R. Fast Screening Method for Assessment of Antimicrobial Activity of Essential Oils in Vapour Phase. Food Res. Int. 2012, 47, 161–165. [Google Scholar] [CrossRef]
- Houdkova, M.; Rondevaldova, J.; Doskocil, I.; Kokoska, L. Evaluation of Antibacterial Potential and Toxicity of Plant Volatile Compounds Using New Broth Microdilution Volatilization Method and Modified MTT Assay. Fitoterapia 2017, 118, 56–62. [Google Scholar] [CrossRef] [PubMed]
- Han, A.; Lee, S.Y. An Overview of Various Methods for In Vitro Biofilm Formation: A Review. Food Sci. Biotechnol. 2023, 32, 1617–1629. [Google Scholar] [CrossRef] [PubMed]
- Zhang, C.; Li, C.; Abdel-Samie, M.A.; Cui, H.; Li, C. Unraveling the Inhibitory Mechanism of Clove Essential Oil Against Listeria monocytogenes Biofilm and Applying It to Vegetable Surfaces. LWT - Food Sci. Technol. 2020, 134, 110120. [Google Scholar] [CrossRef]
- Liu, T.; Kang, J.; Liu, L. Thymol as a Critical Component of Thymus vulgaris L Essential Oil Combats Pseudomonas aeruginosa by Intercalating DNA and Inactivating Biofilm. LWT - Food Sci. Technol. 2021, 136, 110354. [Google Scholar] [CrossRef]
- Azeredo, J.; Azevedo, N.F.; Briandet, R.; Cerca, N.; Coenye, T.; Costa, A.R.; Desvaux, M.; Di Bonaventura, G.; Hébraud, M.; Jaglic, Z.; Kačániová, M.; Knøchel, S.; Lourenço, A.; Mergulhão, F.; Meyer, R.L.; Nychas, G.; Simões, M.; Tresse, O.; Sternberg, C. Critical Review on Biofilm Methods. Crit. Rev. Microbiol. 2017, 43, 313–351. [Google Scholar] [CrossRef]

| Compound | CAS number | Solubility [mmol/l] | Solubility [mg/l] |
|---|---|---|---|
| α-pinene | 80-56-8 | 0.035 – 0.039 | 4.80 – 5.27 |
| Carvacrol | 499-75-2 | 6.65 – 8.32 | 999 – 1,250 |
| Carvone | 6485-40-1 | 8.65 – 11.0 | 1,300 – 1,652 |
| Citral | 5392-40-5 | 1.58 – 3.80 | 241 – 578 |
| Eucalyptol (1,8-cineole) | 470-82-6 | 20.1 – 22.0 | 3,100 – 3,388 |
| Eugenol | 97-53-0 | 15.0 | 2,463 |
| γ-Terpinene | 99-85-4 | 0.064 | 8.68 |
| Geraniol | 106-24-1 | 5.00 | 771 |
| Limonene | 138-86-3 | 0.064 – 0.220 | 8.71 – 30.0 |
| Linalool | 78-70-6 | 9.71 – 12.0 | 1,498 – 1,851 |
| Menthol | 89-78-1 | 2.92 | 456 |
| p-Cymene | 99-87-6 | 0.174 – 2.98 | 23.3 – 400 |
| Thymol | 89-83-8 | 5.70 – 6.65 | 856 – 999 |
| Trans-cinnamaldehyde | 14371-10-9 | 14.0 | 1,850 |
Disclaimer/Publisher’s Note: The statements, opinions and data contained in all publications are solely those of the individual author(s) and contributor(s) and not of MDPI and/or the editor(s). MDPI and/or the editor(s) disclaim responsibility for any injury to people or property resulting from any ideas, methods, instructions or products referred to in the content. |
© 2024 by the authors. Licensee MDPI, Basel, Switzerland. This article is an open access article distributed under the terms and conditions of the Creative Commons Attribution (CC BY) license (https://creativecommons.org/licenses/by/4.0/).
